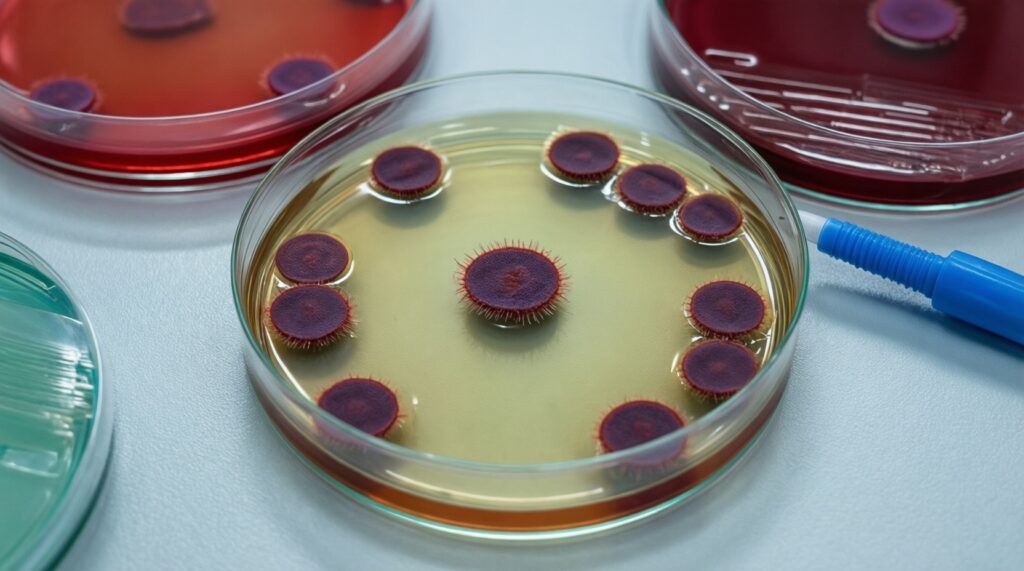
Антибиотикорезистентность: почему бактерии

Антибиотикорезистентность - это способность бактерий выживать при воздействии антибиотика, который раньше их подавлял. Бактерии не "умнеют", а быстро отбирают и передают полезные для выживания изменения: мутации, защитные ферменты, насосы выведения и обмен генами. Практический вывод: лечить нужно по показаниям и по данным чувствительности, снижая ненужное давление антибиотиками.
Краткий обзор механизмов и значимости резистентности
- Резистентность формируется через мутации и горизонтальный перенос генов (плазмиды, транспозоны), поэтому распространяется быстрее, чем кажется по клинике.
- Ключевые механизмы: разрушение антибиотика ферментами, изменение мишени, снижение проникновения и активный вывод препарата.
- Главный ускоритель - "лишние" антибиотики (самолечение, слишком широкие схемы, неправильная длительность/дозы).
- Опора на бакпосев с определением чувствительности к антибиотикам и локальные данные повышает шанс эффективной терапии и снижает селекцию устойчивых штаммов.
- В условиях ограниченных ресурсов даже базовые меры (правильный забор материала, деэскалация, контроль длительности) дают заметный эффект.
Молекулярные механизмы: как бактерии становятся устойчивыми
Антибиотикорезистентность - это не "привыкание организма", а результат естественного отбора: в популяции бактерий выживают те варианты, у которых есть генетические изменения, мешающие антибиотику работать. Эти изменения могут возникать как точечные мутации (например, в белке-мишени) или приходить извне через горизонтальный перенос генов (плазмиды с ферментами устойчивости).
Понятие включает врождённую (интринзик) устойчивость (когда вид бактерий изначально плохо пропускает препарат или не имеет мишени) и приобретённую (мутации/плазмиды). Отдельно важна толерантность (переживание без роста) и персистирование (малые субпопуляции, переживающие терапию): клинически это выглядит как "не добили", хотя МИК может быть в диапазоне чувствительности.
Практическая рекомендация: при клинической неэффективности не "добавляйте второй антибиотик наугад" - сначала проверьте, не ошибка ли это в источнике инфекции (дренирование/удаление катетера), дозировании, проникновении в очаг и качестве забора материала.
| Механизм резистентности | Как работает | Клинические подсказки (не диагноз) | Что сделать на практике |
|---|---|---|---|
| Ферментативная инактивация | Бактерия вырабатывает ферменты, разрушающие/модифицирующие антибиотик | Отсутствие эффекта на "логичной" терапии; быстрый рецидив при сохранении очага | Запросить профиль чувствительности; перейти на препарат/класс, устойчивый к этому механизму, и обеспечить контроль источника |
| Изменение мишени | Структура белка-мишени меняется, антибиотик хуже связывается | Неожиданная устойчивость у типичного патогена; провалы при монотерапии | Подтвердить возбудителя и чувствительность; избегать повторного назначения того же класса без данных |
| Снижение проникновения (порины/барьеры) | Антибиотик хуже попадает внутрь клетки | Слабый ответ при инфекциях с высоким инокулюмом; хуже эффект в труднодоступных очагах | Оценить дозу/путь введения и фармакокинетику в очаге; при необходимости сменить класс/усилить доставку (в т.ч. парентерально) |
| Эффлюкс-насосы | Активное выведение антибиотика из клетки | "Плавающая" клиника: частичный эффект, затем ухудшение; множественная устойчивость к разным классам | Не повышать дозу бесконтрольно; ориентироваться на лабораторные данные и выбирать класс, менее чувствительный к эффлюксу |
| Биоплёнки | Матрикс защищает бактерии, снижает доступ антибиотика, повышает персистирование | Катетер-ассоциированные инфекции, хронические раны, повторные обострения | Удаление/замена устройства, санация очага; антибиотик - как часть комплексной тактики, а не единственное решение |
Факторы, ускоряющие распространение резистентных штаммов
- Ненужные назначения: вирусные ОРВИ, "на всякий случай" при низкой вероятности бактериальной инфекции.
- Слишком широкий старт без плана деэскалации: давление отбирает устойчивые варианты в микробиоте.
- Неправильные дозы/длительность: субоптимальные концентрации и преждевременная отмена повышают шанс выживания части популяции.
- Самолечение и свободный доступ к препаратам (на практике запрос "антибиотики купить" часто означает попытку обойти диагностику и контроль).
- Плохой инфекционный контроль: руки, поверхности, потоки пациентов, повторное использование расходников.
- Передача генов между бактериями в стационаре и сообществе, особенно при высокой антибиотик-нагрузке.
Практическая рекомендация: внедрите правило "48-72 часа пересмотра" - старт по показаниям, затем корректировка по клинике и данным микробиологии с обязательной фиксацией плана (продолжать/сузить/отменить).
Последствия для медицины и общественного здоровья

- Эмпирическая терапия чаще промахивается: растёт доля пациентов, которым нужен пересмотр схемы и/или госпитализация.
- Удлиняется течение инфекций и возрастает риск осложнений, потому что эффективный препарат подбирается не сразу.
- Сужается выбор пероральных опций в амбулаторной практике: приходится чаще использовать парентеральные пути или направлять в стационар.
- Растёт роль контроля источника (дренирование, удаление катетера) - антибиотик перестаёт быть "единственным инструментом".
- Нагрузка на лаборатории: чаще нужен анализ на антибиотикорезистентность и отслеживание локальных профилей.
Практическая рекомендация: для частых синдромов (цистит, пневмония, кожные инфекции) держите краткий локальный алгоритм выбора стартовой терапии и критерии, когда обязательно брать материал на посев.
Диагностика и мониторинг: что должен уметь клиницист
Мини-сценарии, которые стоит отрабатывать как "рефлекс" перед выбором антибиотика:
- До первой дозы: есть ли материал, который нужно взять сейчас (кровь на посев, моча, мокрота, раневое отделяемое), и не испортит ли старт терапии интерпретацию?
- Через 48-72 часа: совпадает ли клиника с ожидаемым ответом, есть ли результат посева/антибиотикограммы, можно ли сузить спектр или отменить?
- Если эффекта нет: это резистентность или проблема источника/дозы/диагноза (абсцесс, обструкция, инородное тело, тромб, неверный очаг)?
Что даёт микробиология (плюсы):
- Подтверждает возбудителя и позволяет таргетировать терапию вместо "широкого покрывала".
- Даёт основу для деэскалации и сокращения ненужной экспозиции антибиотиков.
- Позволяет вести локальный мониторинг устойчивости для обновления эмпирических схем.
Ограничения и ловушки интерпретации (минусы/риски):
- Качество забора: контаминация и неправильная транспортировка дают ложные ориентиры.
- Время: результат позже клинического решения, поэтому нужен план пересмотра.
- Колонизация vs инфекция: рост бактерий не всегда означает, что они причина симптомов.
- Антибиотикограмма не заменяет оценку проникновения в очаг и необходимости контроля источника.
Практическая рекомендация: назначая бакпосев с определением чувствительности к антибиотикам, фиксируйте в истории три пункта: откуда материал, когда взят относительно первой дозы, и какой клинический вопрос вы хотите закрыть (эскалация/деэскалация/отмена).
Практические стратегии снижения риска в амбулаторной и стационарной практике
- Ошибка: лечить "температуру" антибиотиком. Что вместо: лечить синдром и вероятный очаг; при низкой вероятности бактериальной инфекции - наблюдение с критериями ухудшения.
- Миф: "чем шире, тем надёжнее". Что вместо: старт по рискам, затем деэскалация по данным; широкий спектр без плана пересмотра повышает селекцию устойчивых штаммов.
- Ошибка: менять антибиотики каждые 1-2 дня без опоры на данные. Что вместо: оценка ответа в разумные сроки, проверка источника и доз, затем смена по результатам.
- Миф: "лучше подольше, чтобы точно". Что вместо: фиксированная цель терапии: клинические критерии, контроль источника, и минимально достаточная длительность по протоколу учреждения.
- Ошибка: полагаться на "примерную цену" и откладывать микробиологию. Что вместо: заранее согласовать с пациентом, что тест на чувствительность к антибиотикам цена зависит от лаборатории и панели, но клинически оправдан при рецидивах, неэффективности и факторах риска резистентности.
- Ошибка: лечить сложные случаи без профиля рисков. Что вместо: при неясной картине заранее обсудить маршрутизацию и условия, когда нужна консультация инфекциониста цена (обычно зависит от формата и учреждения), но клиническая ценность - в коррекции тактики и снижении ненужной полипрагмазии.
Варианты для ограниченных ресурсов:
- Если нет быстрого доступа к расширенной панели: берите материал на базовый посев до антибиотика и применяйте правило 48-72 часов пересмотра.
- Если посев недоступен: используйте синдромные алгоритмы и локальные данные учреждения; избегайте комбинаций "на всякий случай".
- Если нет инфекционного контроля на уровне отделения: начните с дисциплины рук, изоляции контактных пациентов по возможностям и стандартизации обработки оборудования.
Разработка новых подходов: антибиотики, альтернативы и политика
Новые антибиотики важны, но без управляемого применения они быстро теряют эффективность. Практически полезнее сочетать три направления: (1) точная диагностика, (2) контроль источника инфекции, (3) ограничение ненужного применения антибиотиков на уровне клиники и региона.
Мини-кейс (ограниченные ресурсы, амбулаторный уровень): пациент с рецидивирующими симптомами после нескольких курсов "широких" антибиотиков без подтверждения бактериальной природы. Цель - остановить цикл селекции устойчивости и вернуть диагностику в начало.
Если нет признаков тяжести: 1) Сформулировать синдром и вероятный очаг 2) До антибиотика взять доступный материал (минимум: моча/мазок/раневое) 3) Назначить симптоматическое + наблюдение/контроль через 48-72 ч 4) Антибиотик - только при критериях бактериальной инфекции Если есть признаки тяжести или иммунодефицит: 1) Немедленный старт эмпирической терапии по рискам 2) Забор посевов до первой дозы (если возможно) 3) Через 48-72 ч деэскалация по результатам и клинике
Практическая рекомендация: в учреждении утвердите короткую "политику антибиотиков" - кто может назначать резервные препараты, как фиксируется пересмотр, и какие синдромы требуют посева до первой дозы.
Ответы на ключевые практические вопросы по антибиотикорезистентности
Что означает "анализ на антибиотикорезистентность" в реальной практике?
Обычно это культуральное выделение бактерии и определение её чувствительности к антибиотикам (антибиотикограмма). Важно, что результат применим к конкретному выделенному возбудителю и конкретному очагу/материалу.
Когда нужен бакпосев с определением чувствительности к антибиотикам, а когда можно без него?
Посев особенно нужен при рецидивах, неэффективности стартовой терапии, тяжелом течении, госпитализации, подозрении на внутрибольничную инфекцию и при наличии устройств (катетеры). При лёгких типичных случаях без факторов риска иногда допустима эмпирика с обязательным пересмотром.
Почему "тест на чувствительность к антибиотикам цена" так различается?
Стоимость зависит от набора антибиотиков в панели, типа материала, необходимости идентификации возбудителя и срочности. Ориентируйтесь не на "дешевле", а на клинический вопрос: что именно нужно решить результатом.
Можно ли заранее понять по симптомам, что возбудитель устойчивый?
Надёжно - нет: клиника редко указывает на конкретный механизм резистентности. Подозрение повышают неэффективность адекватной терапии, повторные рецидивы, недавние антибиотики и стационарные контакты.
Почему попытка "антибиотики купить" без врача часто ухудшает прогноз?
Самолечение обычно означает неверный выбор препарата, дозы и длительности, а также пропуск диагноза, где нужен контроль источника. Это повышает шанс селекции резистентных бактерий и осложнений.
Когда действительно полезна консультация инфекциониста и как к ней подготовиться?
Полезна при сложных/рецидивирующих инфекциях, иммунодефиците, подозрении на резистентный патоген и при необходимости длительной терапии. Подготовьте список ранее принятых антибиотиков, даты, результаты посевов и текущие препараты; консультация инфекциониста цена зависит от формата и учреждения.



